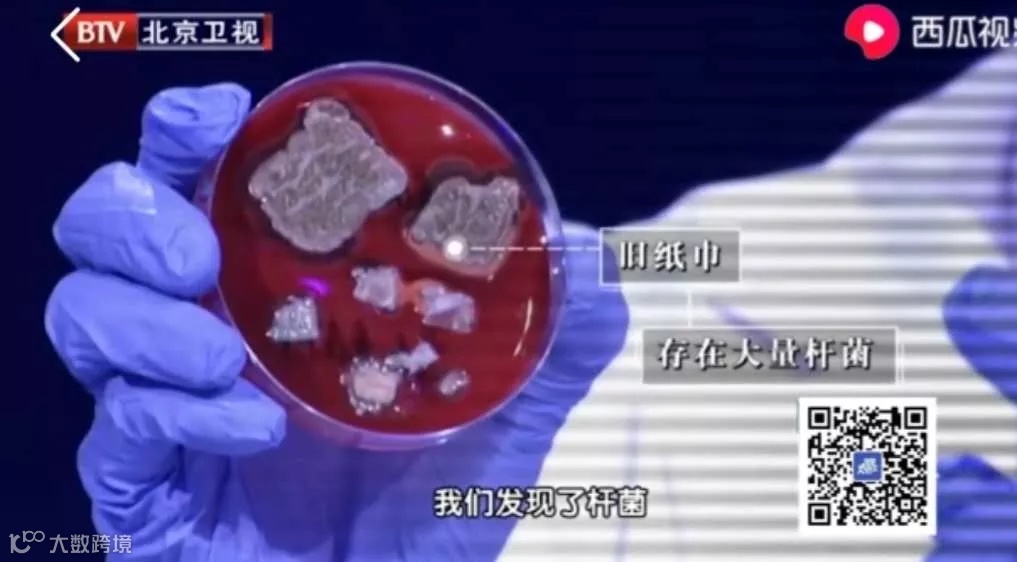

小编搬砖不易,阅读之前先给我们一波“关注”+“星标”吧~


每次去超市买买买,少不了要囤点纸巾。
问问大家:你买纸巾的时候,最关注的是什么呢?是厚度、纸量、价格,还是安全性?
其实说到纸巾,肯定有很多人担心荧光剂的问题,会倾向于购买看起来没有荧光剂的产品。所以,近些年黄色纸巾越来越受欢迎。
更有一些朋友,自己学着网上的方法,用荧光检测笔在白色纸巾上照出了荧光,纷纷发帖“避雷”。
这些操作,到底科不科学呢?
在纸巾生产过程中,通过在原材料、制造工艺方面下功夫,也能提高纸巾的亮度。
比如说,在纤维原料处理工艺上对纤维色素进行脱除,纤维的色素脱除程度越高,则亮度越高。
事实上,目前国内关于纸巾的执行标准中,GB/T20808《纸巾》国家标准、GB/T20810《卫生纸》国家标准、以及QB/T4509《本色生活用纸》行业标准,均不允许产品含有可迁移性荧光物质。


所以,只要从正规渠道购买合格产品,就不必太担心荧光剂问题。
反之,如果不符合国标要求,哪怕它黄黄的、看起来很“纯天然”,也有可能添加了黄色染料,以及各种用于软化及漂白的化学药剂。
Tips:
①认准符合上述国标的产品。

②“100%原生木浆”优于“100%纯木浆”。前者用的是新原料,而后者可能混有回收或再生二手原料。
荧光笔测荧光剂,靠谱吗?
除了看颜色外,网络上流传最广的办法,就是用荧光笔照射,一旦发现荧光反应,就说明该产品含荧光剂。
不只是纸巾,这个自测法也被用在纸尿裤、面膜、洗衣液、洗脸巾等一系列日用品身上,前段时间网上热议的卫生巾,也有不少人用这个办法测出了荧光剂。

图源:壹图网
其实这个方法是不严谨的,它本质上混淆了荧光增白剂和荧光物质的概念。
并非所有带荧光的物质都是荧光增白剂,日常生活中能产生荧光反应的物质并不少见,如萤火虫、人的指甲、水果……
还有部分化妆品原料,如牛油果树果脂、积雪草提取物等,在荧光笔的照射下也会产生的蓝紫色的荧光反应。
所以,看见荧光就说加了荧光增白剂,这种操作简直是“一竿子打翻一船人”。
纸巾是否含有可迁移的荧光增白物质,需要通过专业的检测鉴别。按照国家规定,不同类型的荧光增白剂需要用到不同的测定方法,包括定性分析法、定量分析法等。
这种纸巾,真不建议你用
不知道你有没有这样的习惯:在包里或口袋中装一包手帕纸,开封后一用就是好几个月;
甚至有些人,会把家里的卷纸撕一些,团一团或叠一叠,然后直接装在衣服口袋......
图源:壹图网
身上带纸巾是个好习惯,但这种“带法”可能存在健康风险。
纸巾的生产通常都是全程在高温下进行。如果包装受损或储存不当,都会让纸张受潮受污染,从而更易滋生细菌、招惹病毒。
试想一下,把开封了的纸巾和手机、钥匙、零钱等公认的“细菌窝”放一起,多脏啊,你还拿它擦嘴、擦屁屁!
北京卫视曾做过一期节目,专门讨论了久置纸巾的污染问题,节目上做了一个实验:在身上携带了48小时的纸巾,细菌含量比新开启的纸巾多得多。
①拆开一包纸巾后尽快用完,以缩短其在空气中的暴露时间,降低其受污染的程度;
②谨记便前洗手、便后由前往后擦,以免从手或肠道传染细菌;
④公厕潮湿且细菌多,其提供的纸巾质量通常也比较差,因此尽量不用公厕里的厕纸。
最后,小编想提醒大家,现在微信改版了,点击下面“家庭医生公众号”关注并“星标”我们,每天第一时间看到最新健康科普知识


右下角,您点一个 和“在看”
和“在看”

和“在看”
和“在看”







